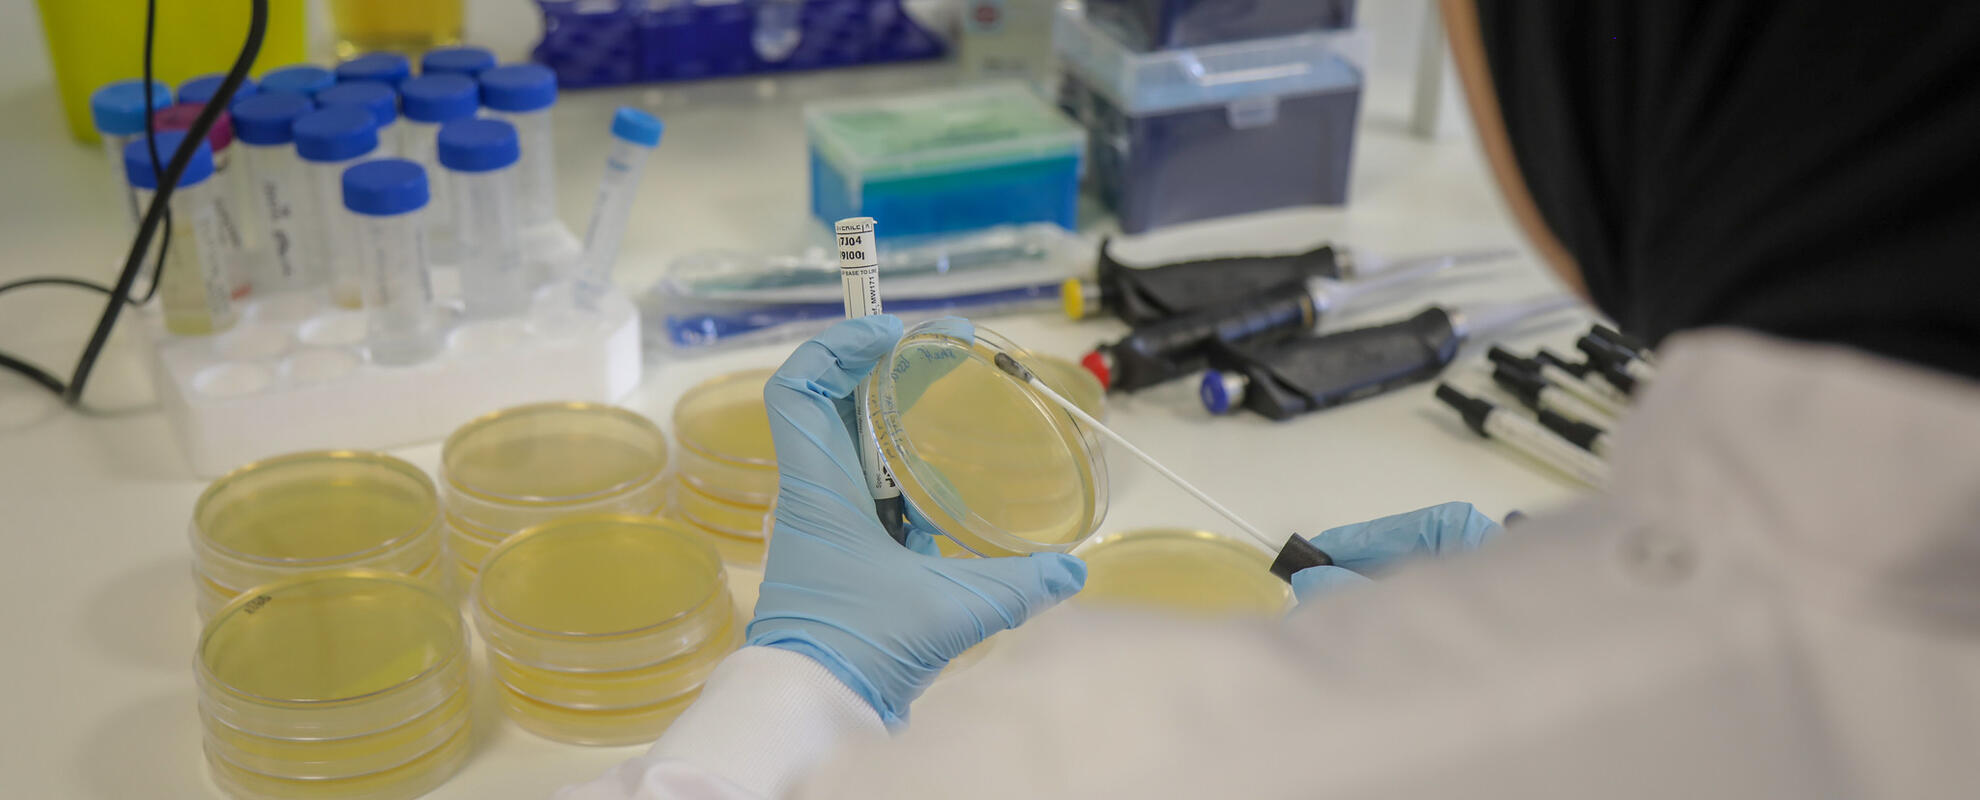

CGIAR Antimicrobial Resistance Hub
CGIAR Antimicrobial Resistance Hub
The CGIAR Antimicrobial Resistance Hub, hosted by the International Livestock Research Institute (ILRI), applies a One Health approach to support efforts in low- and middle-income countries to mitigate risks of agriculture-associated antimicrobial resistance . The hub contributes to ILRI's Animal and Human Health program and leads the antimicrobial resistance component of the ILRI-hosted One Health Research, Education and Outreach Centre for Africa.
In line with the CGIAR antimicrobial resistance strategy that recognizes the need for evidence linking antimicrobial resistance in agriculture and public health outcomes, the CGIAR Antimicrobial Resistance Hub supports the development of evidence-based interventions that are locally relevant and applicable. Research on how to best implement and scale workable solutions is embedded in capacity development activities and supported through advocacy for enabling policies. These research pillars rest on effective transdisciplinary partnerships.
Antimicrobial resistance is a silent pandemic that has mobilized scientists, international agencies, governmental institutions and relevant stakeholders to reduce imprudent antimicrobial use and reduce antimicrobial resistance transmission between different ecological niches.
Antimicrobial resistance is a complex biological issue that requires understanding of social, economic and political drivers. A key aim of the hub is to convene different stakeholders and value chain actors to influence the antimicrobial resistance agenda by facilitating collaborations and new research partnerships and enabling effective communication around agricultural-associated antimicrobial resistance.
CGIAR is well positioned to address agriculture-related antimicrobial resistance risks and their implications for human health in low- and middle-income countries. Through the CGIAR Research Programs on Agriculture for Nutrition and Health (led by the International Food Policy Research Institute), Livestock (led by ILRI) and Fish (led by WorldFish) and involvement of the International Water Management Institute, scientists at CGIAR and international research partners develop multi-sectoral activities to better understand, improve and design innovative strategies to tackle antimicrobial resistance in low- and middle-income countries.




